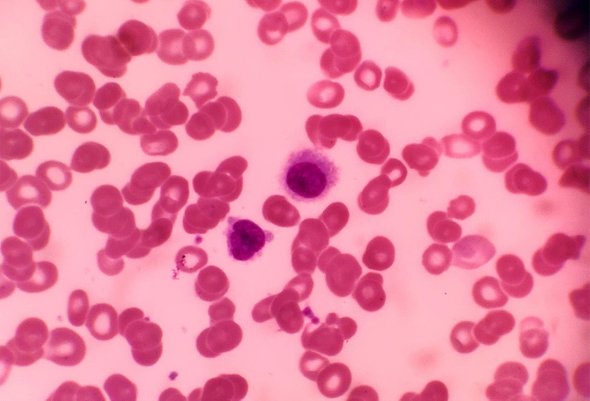

«Я не хочу никого пугать»: многодетные мамы с онкодиагнозом — о том, как говорить об этом с детьми
Мы стараемся защитить и оградить детей от травмирующей, жестокой, пугающей информации. Но что делать, если непростой диагноз стал частью жизни? Если родители заболели и вынуждены уехать в больницу, оставить детей и начать долгое лечение? В блоге Фонда борьбы с лейкемией — рассказ многодетных мам, которым пришлось рассказать об онкологическом диагнозе детям.
Онкологический диагноз, как и любое другое тяжелое заболевание, — испытание не только для пациента. Фонд борьбы с лейкемией уже 10 лет помогает взрослым с диагнозом «рак крови». У большинства подопечных есть дети. Мамы и папы с онкологией часто надолго разлучаются с семьей из-за курсов терапии.
24 сентября, во Всемирный день борьбы с лейкозом, мы решили поговорить с подопечными ФБЛ о том, как они выстраивали отношения с детьми во время многомесячного лечения. А онкопсихолог фонда дала рекомендации, которые помогут оградить ребенка от излишнего стресса во время болезни родителя.
«Старалась не перекладывать на детей свои сложности»
У Алсу Бадаевой из Казани шестеро детей. После рождения младшего сына ее самочувствие стало резко ухудшаться. Весной 2022 года, когда сыну было чуть больше двух месяцев, Алсу поставили диагноз — «диффузная В-крупноклеточная лимфома».
Новорожденный Володя, 4-летний Даниз, 9-летняя Саша, 13-летний Эльдар и 14-летний Раис остались с отцом — Владимиром. Старшая дочь Виктория на тот момент училась в колледже в другом городе. Поскольку на Владимире, помимо основной работы, были заботы о хозяйстве и он не успевал заниматься детьми, тем более грудничком, забота о детях легла на плечи бабушки — она уволилась с работы и взяла на себя воспитание внуков.
«Период постановки диагноза занял некоторое время. Старшие дети Раис и Эльдар привыкли к тому, что я всегда энергичная и веселая. А теперь я возвращалась из больницы еле-еле. Сыновья удивлялись, что меня так долго не могут вылечить. Тогда я и сама не подозревала, что со мной», — делится Алсу.

Когда заболевание диагностировали и Алсу уехала на лечение в Москву в НМИЦ гематологии, старшим детям рассказали, что мама тяжело заболела, правда, опустив подробности.
«Вообще я старалась не перекладывать на детей свои сложности, справлялась сама», — рассказывает Алсу. Даже в больничной палате она старалась оставаться мамой: онлайн заказывала детям одежду, звонила.
Когда вернулась домой, боялась, что младший сын Володя не вспомнит, что она его мама, потому что вместе они были совсем недолго. Но сын быстро привык. Зато старшие дети, по словам Алсу, несколько отдалились и стали «колючими». Она списывает это на подростковый возраст и просто старается быть ближе к сыновьям, оставаться чуткой, доброй, поддерживающей мамой.
Дочка Саша, которой сейчас 11 лет, учится в пятом классе. Она круглая отличница, и Алсу ею очень гордится: «А вот Даниза, который на 2 года младше Саши, немного упустили. Меня не было в его жизни как раз в тот момент, когда я была ему нужна. Ему было четыре, когда я оказалась в больнице, и он не понял, что произошло. Без меня он стал много времени проводить с гаджетами. Даниз заменил этим нехватку материнской любви. Разобрался и начал вести на YouTube блог. Представляете? Сейчас я записала его на хоккей и в бассейн. Везде его сама вожу. Говорю, что я лечилась специально, чтобы теперь быть с ним рядом».
«Не хочу никого пугать»
Дарья Алексеева живет в деревне под Омском и воспитывает с мужем четверых детей. Впервые болезнь дала о себе знать в сентябре прошлого года, а в декабре в НМИЦ гематологии в Москве Дарье поставили диагноз «миелодиспалстический синдром с избытком бластов».
Сейчас Дарья лежит в больнице и проходит очередную химиотерапию. Детьми занимается ее муж Фёдор. Он фермер, на нем лежит ответственность за детей и за хозяйство, которое кормит семью.
«Старшая дочь Лиза — ей сейчас 13 — помогает папе по дому. Они с 10-летней Ритой за время моего лечения сильно повзрослели. Ведь я, даже когда из больницы приезжаю домой, часто не могу ничего делать. А они пол моют, еду готовят, стирку ставят, за трехлетним Валерой присматривают. В основном с ним, конечно, возится муж, но, когда он в поле, девчонки нянчат», — говорит Дарья.
Четвертый ребенок Дарьи и Федора — маленькая Злата. Ей всего год и три месяца. Когда Дарья оказалась в больнице, девочкой начали заниматься муж и бабушка. Сейчас Злату отдали в ясли — в районе, где живет бабушка.

«Когда мне поставили диагноз, я сразу объяснила старшим девочкам, что у меня болезнь крови — фактически рак. Сами понимаете, в деревне быстро все новости разносятся. Как-то Рита пришла из школы и плачет: «Мама, а у тебя выпадут волосы?» Я сказала ей: «Да, но ничего страшного. Я уже парики себе выбираю. Скоро мама будет в разных образах ходить». Объяснила дочке, что волосы вырастут, что главное — лечиться.
Вообще Маргарита у нас более эмоциональная, она переживает за меня, скучает, когда долго не видит. У Лизы я не вижу особой тревоги. Она спрашивает о моем самочувствии, но Лиза, как любой подросток, более самостоятельная. Может быть, поэтому и к болезни моей она относится спокойнее», — делится Дарья.
Она рада, что дочки не забросили школу, стараются хорошо учиться: «В целом дети приняли ситуацию с моей болезнью спокойно. Я и сама не делала из этого трагедии, не устраивала истерик. У меня четверо детей, мама, сестры, друзья — я не хочу никого пугать», — рассказывает Даша.
Когда она в больнице, связывается с близкими по телефону. Вот только видеозвонки не любит. Говорит, что начинает плакать, особенно когда видит маленькую Злату: «Чаще эсэмэс и голосовые сообщения детям отправляю, они мне записывают видео».
Нужно ли рассказывать ребенку о своей болезни

Ассистент кафедры педагогики и медицинской психологии Первого МГМУ имени И. М. Сеченова, онкопсихолог Фонда борьбы с лейкемией Камилла Шамансурова отвечает на этот вопрос так: «Каждая семья индивидуальна, поэтому нельзя обобщить и сказать, как правильно.
Если в семье принято обсуждать чувства и переживания детей и родителей — это одна ситуация. Если родители знают, что ребенок впечатлительный и в результате любого эмоционального потрясения у него нарушается сон, начинаются проблемы в детском саду или школе, то не совсем правильно рассказывать ему всё.
Кроме того, многое зависит от возраста: у ребенка двух и 16 лет совершенно разные потребности в информировании.
Лечение влияет на внешность, состояние, возможности родителя. В какой-то момент мама или папа могут настолько измениться, что ребенок начнет сам задавать об этом вопросы. И кто-то станет уходить от ответа, а кто-то, наоборот, понемногу раскрывать суть происходящего: «Я сейчас прохожу трудное лечение, доктор назначает мне серьезные процедуры, но всё это для того, чтобы я смог (ла) выздороветь. Я могу уставать, злиться. Но это потому, что я болею и прохожу сложное лечение, ты в этом не виноват».
Сейчас у детей есть доступ практически к любой информации. И если у ребенка есть вопрос, он будет искать ответ на него в интернете. Насколько правильно он поймет то, что прочитает там, мы не знаем. Вряд ли он найдет информацию, написанную понятным ему языком. Поэтому иногда есть смысл родителю сесть и рассказать, что происходит. Рассказать аккуратно, не упоминая все риски.
Мы не должны пугать ребенка, мы должны сказать ему, что прежде всего остаемся семьей
И если мама или папа сейчас уехали лечиться, это не значит, что происходит что-то плохое. Это значит, что мы вместе помогаем маме или папе выздороветь. Мы не знаем, как долго это будет, но мы делаем всё, чтобы справиться.
Стоит дать ребенку время на осознание. Не нужно сразу вести его к психологу. Он может и сам разобраться в каких-то моментах. Ему нужно прийти к тому, что болезнь — это часть жизни и это нормально. То есть ребенку нужно время, чтобы самому сделать выводы.
Моя коллега проводила опрос среди работающих матерей, которые заболели онкологией и ничего не сказали об этом детям. Это было не количественное, а качественное исследование, по результату которого был сделан вывод, что так поступить было абсолютно нормально. Это не навредило детям. То есть для каждой ситуации, каждой семьи, каждого человека есть свое решение.
Но важно знать, что у каждого решения есть и свое последствие. Если родитель выбрал скрыть от ребенка заболевание, то нужно понимать, что придется не говорить и о многом другом. Например, скрывать свое плохое самочувствие.
Но заболевание очень непредсказуемо — человеку может стать плохо внезапно. Тогда ребенок неожиданно окажется в непредвиденных для него обстоятельствах. Поэтому, если вы не говорите о диагнозе, то всё же не нужно создавать иллюзии абсолютно здорового человека.
Полный рассказ тоже имеет свои особенности. Например, вы можете не знать ответов на все вопросы, которые задает ребенок. Вы можете уставать, и у вас может не быть желания отвечать.
Диагноз — это момент развития. Меняется не только человек, но и семья. Кто-то принимает решение развестись, кто-то уходит с работы, кто-то просто замыкается. Дети пытаются всё это понять и осмыслить. И иногда в этом анализе им можно помочь».
Вы находитесь в разделе «Блоги». Мнение автора может не совпадать с позицией редакции.
Обложка: Frawash / Shutterstock / Fotodom











